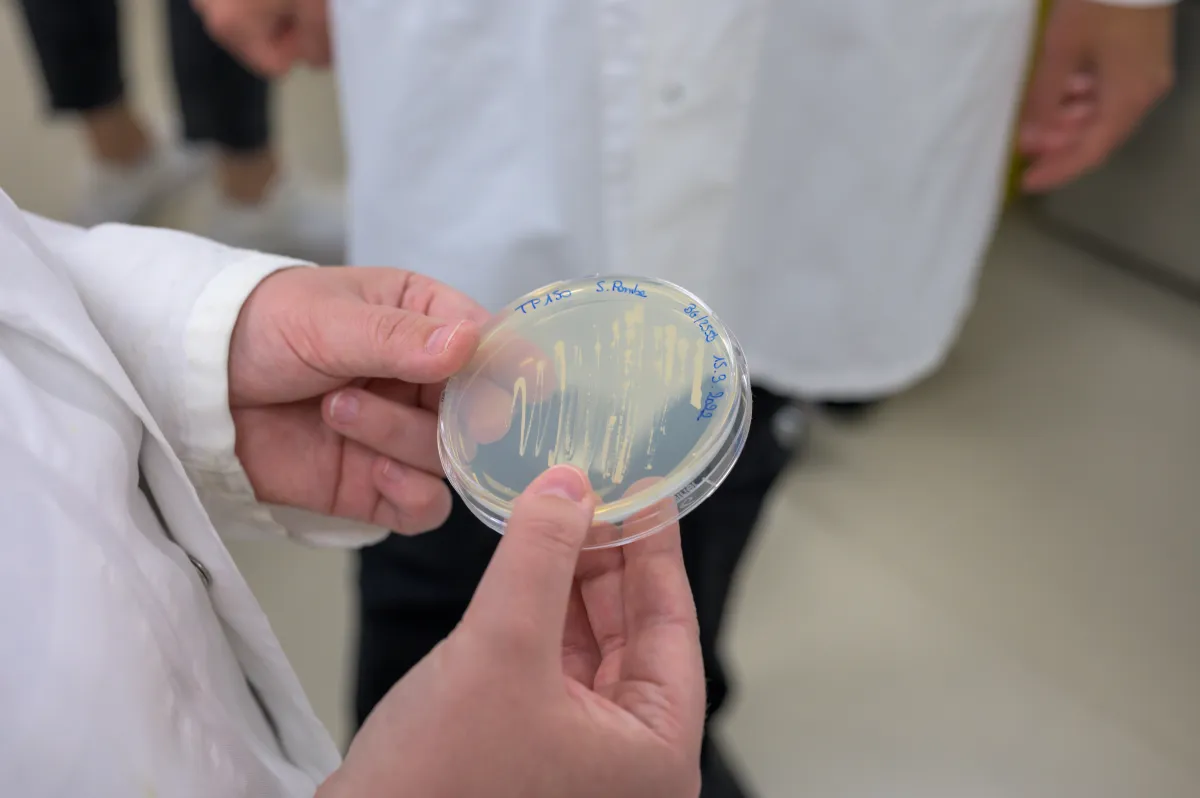

Antoine Jégou What are the ingredients needed to build, diversify and maintain the skeleton of a cell?
Antoine Jégou, CNRS research director, Institut Jacques Monod, Paris, France
- 2022 • Impulscience



By forming filaments and networks, actin is a key component in maintaining the shape of cells. In microfluidic chambers, Antoine Jégou recreates the constraints actin filaments are exposed to in cells to study how different actin networks are constructed and cohabit.
The actin network: a host of forms for a multitude of functions
Actin, a very abundant protein in our cells, can self-assemble to form filaments, which then form networks. This allows the cells to keep their shape, move, grow and divide as a kind of cell skeleton. Actin filaments have a wide range of shapes, sizes and mechanical properties. In addition, some proteins capable of associating with actin strongly contribute to defining the identity of each network. Lacking accurate measurements, researchers do not yet understand how the identity of actin networks is established and maintained. How can networks with surprisingly different structures and assembly dynamics coexist in a cell? How do actin-associated proteins target a particular network rather than the neighboring one?
Microfluidics to the rescue
The different actin networks have different properties because of their content, their combination with other proteins and mechanical constraints. Interactions between these multiple factors are important in determining the identity and function of actin networks. How can they be studied? One way is to recreate actin networks outside the cell in vitro by adding all the factors involved in their construction and function one by one. The factors must be sequentially and quantitatively studied, from the level of individual filaments to networks, while controlling many parameters. Antoine Jégou's team is preparing to meet this major technical challenge with microfluidics, a technology he has been developing in his laboratory for over 10 years.
Like in the cell
The microfluidic chambers Dr. Jégou proposes to use are very narrow, typically measuring one millimeter wide and only 20 micrometers high. In them he can place and observe one or more kinds of about a hundred actin filaments at the same time, subject them to various constraints and expose them to different proteins and forces. The filaments will grow more or less and interact with each other and with different proteins that will change their shape and mechanical properties. Dr. Jégou's team members will leave no stone unturned to recreate the situations filaments encounter in a cell. The team will study combinations of factors and use automated analytical methods to provide new insights into the intertwined/interdependent processes that govern actin network identity in cells.
Antoine Jégou in a few words
Antoine Jégou studied telecommunications engineering and worked for a mobile telecommunications company in Europe and Asia before turning to basic research in biophysics and obtaining a PhD in that field in 2008. During his post-doctoral fellowship at the structural enzymology and biochemistry laboratory on the Gif-sur-Yvette CNRS campus, he studied actin biochemistry and developed new tools to study actin dynamics at the single filament level. In October 2014, together with Guillaume Romet-Lemonne he co-founded a research group at the Institut Jacques Monod in Paris. Since then, they have addressed key questions about how actin-binding proteins interact with actin filaments. Dr. Jégou received support from the ERC (starting grant) in 2016.

Impulscience
Impulscience allocates 7 new grants each year to researchers in the life sciences. Focused on the mid-career, this program aims to support this crucial stage for the development of research projects.
All the award-winnersCall for applications
Online applications open on 7 April 2026 and close on May 21, 2026 for candidates who responded to ERC Starting or Consolidator 2025 calls ; on June 22, 2026 for candidates who responded to ERC Advanced 2025 call.